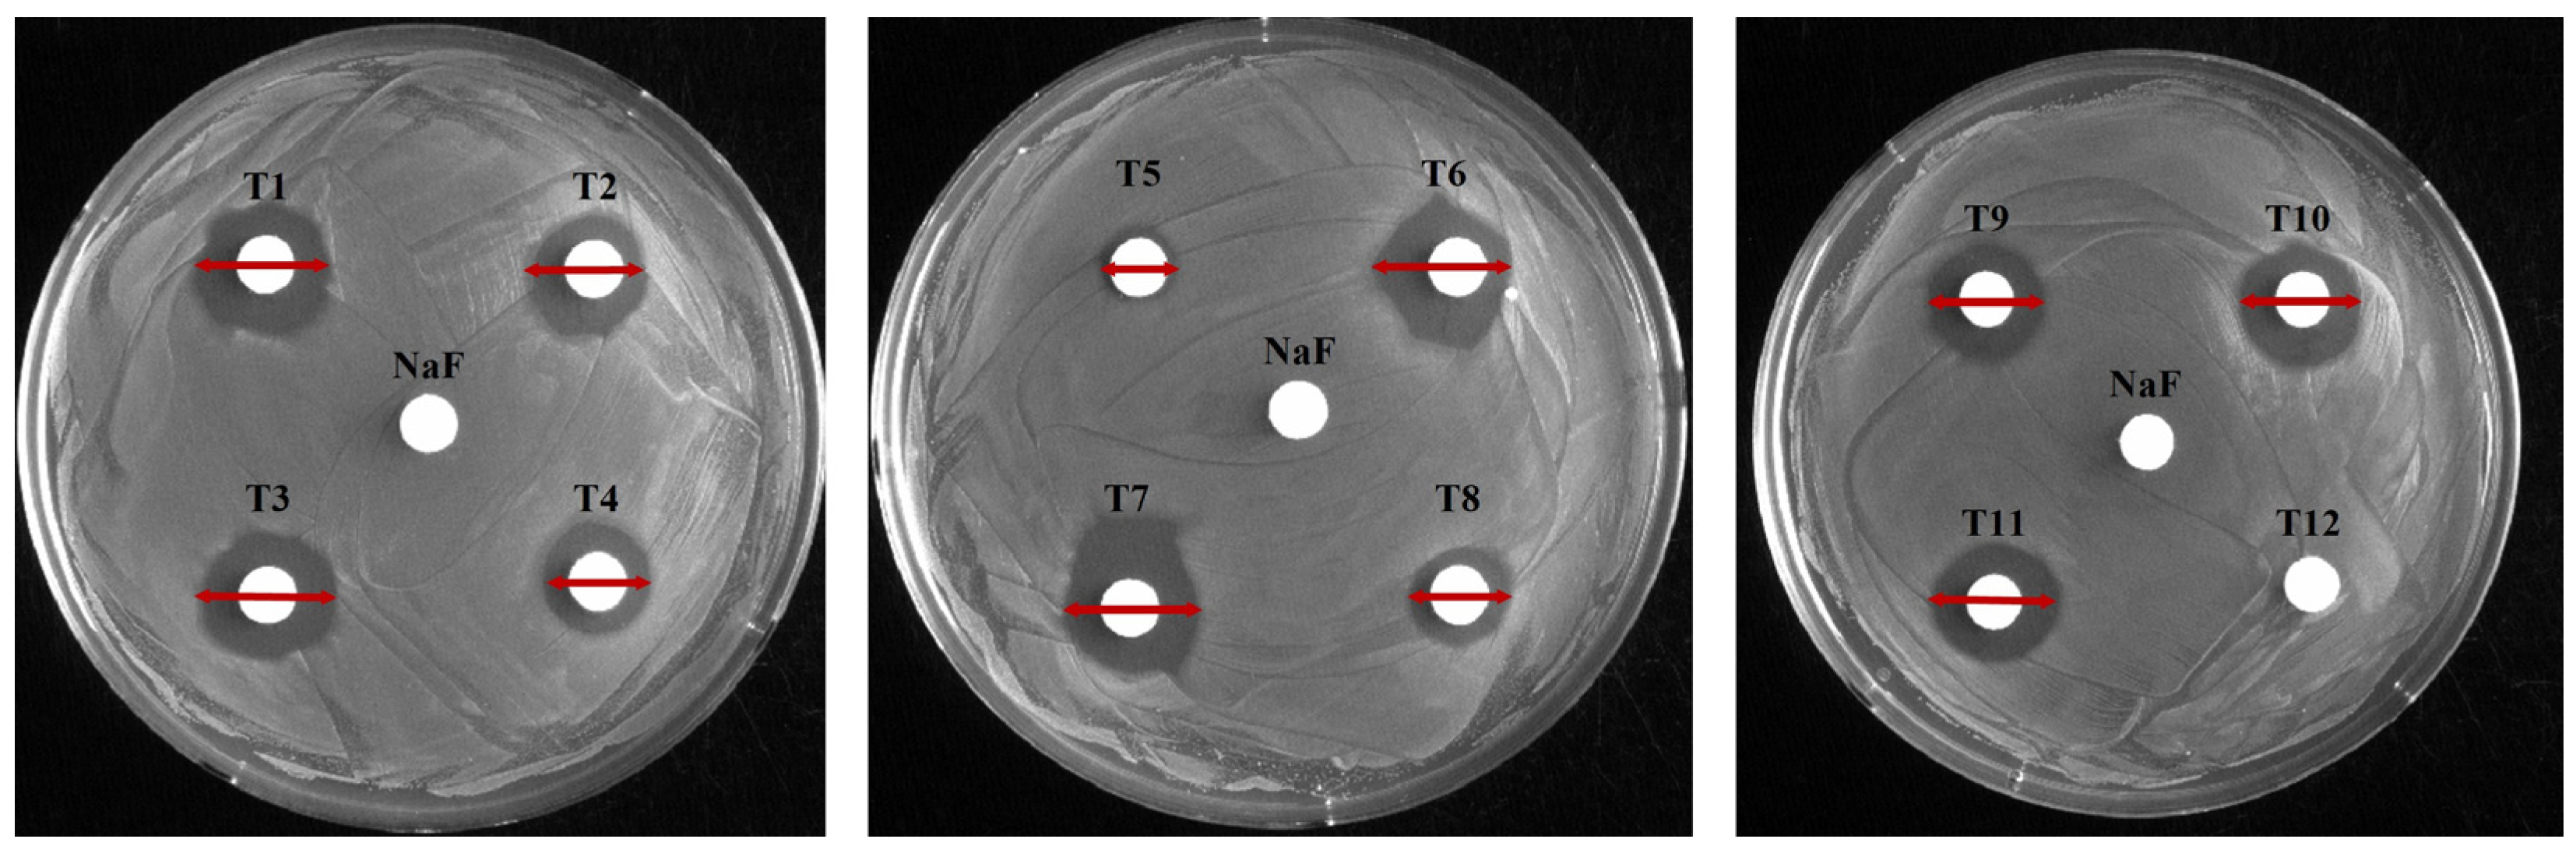
Applbiosci 04 00038 g001 Applbiosci 04 00038 g001

Abstract
Toothpaste is an essential oral hygiene product commonly used to sustain oral health due to its incorporation of antimicrobial agents. Numerous functional toothpastes enriched with antimicrobial agents have been developed and are available to consumers. This study evaluates the antimicrobial and antibiofilm efficacy of 12 commercially available toothpaste products, including those with specialized functions. Statistical significance was assessed to validate the differences observed among the toothpaste samples. Their effects on Streptococcus mutans, the primary pathogen responsible for dental caries, were evaluated. The minimum inhibitory concentration (MIC) and minimum bactericidal concentration (MBC) were determined, and bacterial growth was measured to compare antimicrobial activities. Toothpaste containing 1000 μg/mL fluoride and whitening toothpaste exhibited the strongest antimicrobial effects, effectively inhibiting S. mutans growth. Additionally, bamboo salt-enriched and tartar-control toothpaste demonstrated inhibitory effects on bacterial growth. Assays to evaluate the ability of cells to form biofilms and the expression of genes involved in biofilm formation revealed a partial correlation between biofilm formation and spaP, gtfB, gtfC, and gtfD expression, although some showed opposite trends. Collectively, this study provides valuable insights into the antimicrobial and biofilm inhibition capabilities of commercial toothpastes against S. mutans, offering a foundation for evaluating the efficacy of functional toothpaste products.
1. Introduction
Toothpaste is a crucial component of oral health care. Oral hygiene’s importance became recognized in the mid-19th century [1]. In the late-19th century, Colgate in the United States began mass-producing toothpaste, standardizing it as an oral hygiene product. Toothpastes typically contain abrasives, surfactants, humectants, flavoring agents, and antimicrobial agents [2,3]. Recently, functional toothpastes containing a variety of ingredients have been widely used not only for routine oral hygiene but also to address specific oral health problems. For example, fluoride-containing anti-caries toothpaste inhibits cariogenic bacteria; hydrogen peroxide-based whitening toothpaste removes stains and enhances tooth brightness; desensitizing toothpaste with potassium nitrate and potassium chloride eases dentin hypersensitivity; and children’s toothpastes are formulated with lower fluoride concentrations and appealing flavors [4,5,6].
Toothpaste contains various components to maintain oral hygiene and protect teeth and gums. Abrasives, such as silicon dioxide (SiO2), calcium carbonate (CaCO3), and calcium phosphate (Ca3(PO4)2), mechanically remove dental plaque and stains without damaging enamel. Surfactants, including sodium lauryl sulfate, improve cleaning by removing food debris and fatty substances, and generate foam that aids in mechanical removal during brushing [7,8]. Meanwhile, fluoride prevents dental caries by inhibiting acid production by cariogenic bacteria [9] and promoting enamel remineralization, including calcium and phosphate [10,11]. Other components, such as humectants, including glycerin and sorbitol, help retain moisture and prevent desiccation of the paste [1,12], while flavoring agents and breath fresheners, including menthol, reduce halitosis and provide a refreshing sensation [1].
Streptococcus mutans is a Gram-positive, facultative anaerobic bacterium and a major oral pathogen responsible for dental caries. Its pathogenicity stems from its ability to form biofilms on teeth [13]. Initially, S. mutans adheres to the pellicle on the enamel via the protein SpaP [14]. Subsequently, S. mutans secretes glucosyltransferases (GTFs), which metabolize glucose to produce glucan, a sticky polysaccharide [15], aiding bacterial attachment and micro-colony formation. These mature into multilayered biofilms, referred to as dental plaque. If untreated, plaque calcifies into tartar. During plaque development, S. mutans accumulates extracellular polymeric substances (EPS), predominantly comprising polysaccharides and proteins, which strengthen biofilm structure and protect against environmental stress. Finally, S. mutans metabolizes carbohydrates into acids, leading to enamel demineralization and dental caries [13].
Fluoride, commonly found in toothpaste, is a key antimicrobial agent against oral pathogenic bacteria, including S. mutans. In acidic environments, fluoride enters bacterial cells as hydrogen fluoride (HF), which dissociates into H+ and F− ions [9]. F− inhibits enolase, disrupting carbohydrate metabolism and glucose uptake, while H+ accumulation causes cytoplasmic acidification, impairing cellular function. Fluoride further reduces S. mutans’ acid tolerance by inhibiting F-ATPase and binding to pyrophosphatase in the presence of Mn2+, preventing survival, acid production, and adhesion to teeth [9,16,17,18]. However, the recent development of functional toothpastes with antimicrobial agents requires further investigation into their effects on S. mutans.
In this study, we hypothesized that the antimicrobial and antibiofilm activities of commercially available toothpastes against S. mutans vary according to their fluoride content and the presence of additional functional ingredients such as hydrogen peroxide and bamboo salt. To test this, we analyzed each toothpaste’s antimicrobial activity, its ability to inhibit biofilm formation, and the resulting changes in the expression of biofilm-related genes in S. mutans. Toothpaste efficacy varied by type, and in some cases antibiofilm effects did not parallel gene expression changes. The findings of this study provide insights for developing functional toothpastes and determining appropriate fluoride concentrations, offering strategies to enhance oral health and prevent caries.
2. Materials and Methods
2.1. Selection of Toothpastes and Bacterial Strain
This in vitro study aimed to evaluate and compare the antibacterial and antibiofilm effects of twelve commercially available toothpastes against S. mutans UA159 under controlled laboratory conditions, using untreated samples as negative controls. Twelve commercially available toothpastes from South Korea, including various functional types, were selected based on ingredient and manufacturer diversity and market preferences according to data from major online platforms (Table 1). The selection included fluoride-free, low-fluoride, and high-fluoride natural, children’s, and general purpose toothpastes, as well as those targeting dentin hypersensitivity, halitosis, whitening, and gum care. The pH of each toothpaste was measured at 100 mg/mL prior to dilution in the respective assay media, and the results are listed in Table 1. To assess antibacterial activity, S. mutans UA159—a representative oral pathogen associated with dental caries—was cultured in Brain Heart Infusion broth (BHI; Difco Laboratories, Detroit, MI, USA) at 37 °C under 5% CO2/95% air atmosphere.

Table 1.
List of toothpastes used for this study.
2.2. Disk Diffusion Assay
The antibacterial activities of selected toothpastes were evaluated using the disk diffusion method [19]. S. mutans was cultured overnight at 37 °C under 5% CO2/95% air, diluted 1:100 (v/v) in fresh BHI broth, and incubated to early logarithmic phase (optical density at 600 nm [OD600] = 0.3–0.5, ≈1.4 × 106 CFU/mL). Subsequently, 100 μL of the culture was spread onto BHI agar plates (1.5% agar) using a sterile triangular spatula. Toothpaste dilutions were prepared in sterile distilled water, with a final concentration of 154.8 mg/mL, corresponding to the estimated in-mouth concentration during a standard 2 min brushing session [20]. Then, 10 μL of each dilution was applied to 6 mm sterilized paper disks placed on the agar surface. As a positive control, 30 mg/mL sodium fluoride (NaF) solution was added to a separate disk. The plates were incubated for 24 h under the conditions described above, after which inhibition zone diameters were measured to assess antibacterial activity.
2.3. Determination of Minimum Inhibitory Concentration and Minimum Bactericidal Concentration
The minimum inhibitory concentration (MIC) of toothpaste against S. mutans was determined using a previously described method [19]. An overnight culture of S. mutans was diluted 1:100 (v/v) into fresh BHI broth and incubated to logarithmic phase (OD600 = 0.3–0.4). In a sterile 96-well plate (SPL Life Sciences, Pochun, South Korea), BHI broth and toothpaste stock solutions (100 mg/mL in sterile distilled water) were combined to a final volume of 300 µL per well, yielding toothpaste concentrations of 0.25, 0.5, 0.75, 1.0, 1.25, and 1.5 mg/mL (and higher concentrations where required). The wells were inoculated with the adjusted S. mutans culture at a 1:100 (v/v) ratio and incubated for 24 h at 37 °C in a 5% CO2/95% air atmosphere. Control wells included growth controls and positive controls with sodium fluoride at final concentrations of 0–5 mg/mL. The MIC was defined as the concentration at which no growth was observed after incubation.
The minimum bactericidal concentration (MBC) was determined by transferring 5 μL of the culture from each MIC dilution into BHI agar and incubating for 24 h. The MBC was defined as the lowest concentration at which no growth or colony formation was observed after incubation [19].
2.4. Quantitative Comparison of Biofilm Formation
Biofilm formation was measured using a plate-based crystal violet staining method [21,22]. S. mutans was pre-cultured in BHI broth, diluted 1:100 (v/v) in fresh broth, and incubated to early logarithmic phase (OD600 = 0.5). The semi-defined biofilm medium (BM) was used to promote stable biofilm formation under defined carbohydrate conditions known to influence biofilm development. BM was prepared by mixing K2HPO4, KH2PO4, (NH4)2SO4, NaCl, MnCl2·4H2O, FeCl3·6H2O, and Casamino acids in distilled water to a final volume of 475 mL to create the base medium (pH 7.4) [23]. Next, MgSO4·7H2O, CaCl2·2H2O, amino acids, vitamins, and carbon sources (1 M glucose and 1 M sucrose [2:1]) were added to the sterilized base medium.
To evaluate the preventive effects of toothpaste on biofilm formation, each toothpaste was first diluted in BM broth to 0.5 mg/mL, 0.75 mg/mL, and 1 mg/mL. A total of 200 μL of the prepared mixture was dispensed into each well of a 96-well plate. The cultures were inoculated at 1:100 (v/v) and incubated for 24 h. The biofilms formed were washed twice with distilled water, stained with 1% Gram Crystal Violet (Becton Dickinson, Franklin Lakes, NJ, USA) for 15 min, washed again with distilled water, and air-dried at room temperature. The stained biofilm was solubilized in a 1:4 (v/v) acetone–ethanol solution, and the absorbance was measured at 570 nm using a Multiskan FC microplate reader (Thermo Fisher Scientific, Waltham, MA, USA).
2.5. Growth Assay
To measure S. mutans growth, the culture was diluted 1:100 (v/v) in fresh BHI broth and incubated to early logarithmic phase (OD600 = 0.3~0.4) [22]. Toothpaste concentrations of 0.5 mg/mL, 0.75 mg/mL, and 1 mg/mL were prepared in BHI medium; 300 μL aliquots were added to 100-well honeycomb plates (Bioscreen C, Helsinki, Finland), inoculated at 1:100, and one drop of sterilized mineral oil was added to each well to maintain anaerobic conditions. S. mutans growth was measured hourly at 600 nm for 24 h at 37 °C using a Bioscreen C plate reader.
2.6. Quantitative Real-Time PCR
S. mutans was cultured in BHI broth, diluted 1:50 (v/v) in fresh broth, and incubated until the OD600 reached 0.6 [19]. Subsequently, 2 mg/mL toothpaste was added, and the culture was incubated for 10 min under the same conditions. Cells were washed with diethylpyrocarbonate (DEPC)-treated water (Enzynomics, Daejeon, South Korea) and resuspended in a mixture of DEPC-treated water and RS buffer, followed by a 5 min reaction at room temperature. Following centrifugation at 13,000 rpm for 10 min at 4 °C, the pellet was resuspended in 50/10 mM Tris–EDTA–SDS buffer (50 mM Tris, 10 mM EDTA, pH 8, 20% SDS) and the cells were disrupted using a bead beater (BioSpec Products, Inc., Bartlesville, Oklahoma) with acidic phenol. RNA was extracted using the Accuprep bacterial RNA extraction kit (Bioneer, Daejeon, South Korea), and its concentration was measured using a NanoDrop 2000 (Thermo Fisher Scientific). Next, cDNA was reverse-transcribed using PrimeScript™ RT Master Mix (Takara Bio, Kusatsu, Japan). The primer sequences used for qPCR are listed in Table 2. qRT-PCR was performed using RbTaq™ SYBR Green qPCR High-ROX PreMIX (Enzynomics) on a QuantStudio 1 Real-Time PCR system (Applied Biosystems, Waltham, MA, USA).

Table 2.
qRT-PCR primers used in this study.
2.7. Statistical Analysis
All experiments were performed in triplicate. Data normality was assessed using the Shapiro–Wilk test. For datasets meeting normality assumptions, comparisons between groups were conducted using Student’s t-test. Statistical significance was set at p < 0.05.
3. Results and Discussion
3.1. Selecting Toothpastes for Evaluating Antimicrobial Activity Against S. mutans
Toothpaste comprises various chemicals, with antibacterial agents particularly effective in preventing dental caries. The effectiveness of toothpaste depends on the interaction and composition of these ingredients, which differ by manufacturer. This study compared 12 toothpastes from nine manufacturers (Table 1).
Eight toothpastes (T1, T2, T4, T6–T10) contained fluoride. T2 was a low-fluoride toothpaste (NaF, 528 μg/mL), whereas T8 and T10 were high-fluoride toothpastes (1450 μg/mL). The remaining fluoride-containing toothpastes had a concentration of 1000 μg/mL. Four toothpastes were fluoride-free (T3, T5, T11, and T12), with T3 containing hydrogen peroxide. In addition, T1, T2, T3, T9, T11, and T12 contained xylitol, a natural sweetener. Sodium lauryl sulfate was present in all toothpastes from T1 to T11, but not in T12.
3.2. Toothpastes with Antimicrobial Activity Against S. mutans
To evaluate antimicrobial activity against S. mutans, 12 toothpastes were analyzed using disk diffusion, MIC, and MBC (Figure 1 and Figure 2; Table 3 and Table 4). In the disk diffusion test, all toothpastes, excluding T12, had inhibition zones, with T1 having the largest (16.17 mm) and T5 the smallest (8.25 mm) inhibition zones. The control NaF (300 μg/mL) showed no inhibition zone (Figure 1, Table 3). These results suggest that T1 exhibits the highest antimicrobial activity. Notably, the lack of inhibition zones in the control group suggests no clear correlation between fluoride content and inhibition zone size. This was further supported by the relatively smaller inhibition zones of high-fluoride toothpastes with 1450 μg/mL fluoride (T8: 11.11 mm, T10: 14.28 mm) compared to those with 1000 μg/mL fluoride (T1). Hence, other chemical components also contribute to antimicrobial activity. In particular, the larger inhibition zone observed in the low-fluoride toothpaste (T3) containing 528 μg/mL fluoride compared to the high-fluoride toothpaste (T8) highlights the need to consider the fluoride release mechanism. The amount of released fluoride can be influenced by the toothpaste composition as well as the chemical composition and pH of the solution and medium [24].

Figure 1.
Evaluation of the antimicrobial activity of toothpaste. The antibacterial effects of each toothpaste were evaluated using a disk diffusion assay. The control disk contained 30 mg/mL NaF; each of the 12 toothpastes was tested at a final concentration of 154.8 mg/mL; red line: diameter (mm) of the inhibition zone.

Figure 2.
Determination of the minimal bactericidal concentration (MBC) of toothpastes and NaF against S. mutans. S. mutans cells, grown to the exponential phase, were inoculated into liquid media containing different concentrations of toothpastes or NaF and incubated for 24 h. After incubation, the cultures were spotted onto BHI agar plates and incubated for 24 h to assess bacterial viability. The numbers indicate the concentrations (mg/mL) of toothpastes or NaF diluted in BHI broth.

Table 3.
Measurement of inhibition zone diameters for each toothpaste.

Table 4.
The value of minimum inhibitory concentration (MIC) and minimum bactericidal concentration (MBC) against S. mutans.
Other toothpaste components also contribute to bacterial growth inhibition. The MICs for S. mutans were 0.75 mg/mL for T1, T3, and T7, 1 mg/mL for T4, T6, T8, T9, and T10, and 1.25 mg/mL for T2 and T11 (Table 4). Generally, lower MIC values suggest stronger inhibition. However, determining the MIC for T5 and T12 was difficult due to their high turbidity; thus, MBC measurements were also performed. The MBCs of T1 and T3 were 0.83 mg/mL and 0.94 mg/mL, respectively, while T12 had the highest MBC (40 mg/mL), confirming the lowest bactericidal effect (Figure 2 and Table 4). Based on the MIC and MBC results, T1, T3, and T7 were identified as toothpastes with the highest antibacterial activity against S. mutans, whereas T12 exhibited the lowest.
The main ingredient of T3, hydrogen peroxide, induces oxidative stress, which kills bacteria [25,26]. In this study, hydrogen peroxide demonstrated antimicrobial effects similar to 1000 μg/mL fluoride toothpaste (T1). Additionally, T7 contains 1000 μg/mL fluoride and bamboo salt. Bamboo salt is produced by filling bamboo with sea salt and baking it nine times over a pinewood fire. This process removes impurities from sea salt and increases its mineral content, including calcium, potassium, copper, and zinc, which may contribute to its antimicrobial activity due to its high alkalinity (pH 11.4) [27,28].
Based on the above results, regular toothpaste with 1000 μg/mL fluoride (T1), whitening toothpaste with hydrogen peroxide (T3), and bamboo salt toothpaste with bamboo salt and 1000 μg/mL fluoride (T7) exhibited greater antimicrobial effects than the high-fluoride toothpaste with 1450 μg/mL fluoride. Thus, the antimicrobial activity of commercial toothpaste is not solely dependent on the fluoride concentration [29,30]. Although fluoride requires an acidic environment to exert its antimicrobial function [9], in this study, a neutral pH was maintained for bacterial growth, which may explain why the antimicrobial effects did not correlate with fluoride concentration. In addition, T2, T6, T8, T9, T10, and T11 had identical MIC and MBC values, confirming that these toothpastes were bactericidal at the tested concentrations.
Although we report single MIC and MBC values for clarity, these metrics represent population-level averages and cannot account for phenotypic heterogeneity within clonal S. mutans cultures. Indeed, some subpopulations may exhibit protracted lag phases, potentially delaying detectable outgrowth under certain conditions.
3.3. Antibiofilm Activity of Toothpastes
A biofilm-forming assay assessed the effects of commercial toothpaste on S. mutans (Figure 3). The sub-MIC concentrations and MIC values of certain toothpastes were applied. At 0.5 mg/mL, a significant reduction in biofilm formation was observed in the T1 and T3 treatment groups compared to the control and NaF control (Figure 3a; p < 0.05). Hence, these toothpastes effectively inhibited biofilm formation. The fluoride in T1 and the hydrogen peroxide in T3 possess antibacterial and antibiofilm properties [31,32]. Meanwhile, treatment with T5 or T12 increased biofilm formation compared with the control group. Similar results were observed at 0.75 mg/mL (Figure 3b), with all toothpastes, excluding T5 and T12, significantly inhibiting biofilm formation (p < 0.05). The increased biofilm formation observed under 0.5 mg/mL T5 and T12 treatment may be attributed to using toothpaste at concentrations lower than the MIC, allowing more bacteria to survive and resulting in greater biofilm formation. Generally, biofilms are protective structures that bacteria form as survival and defense mechanisms. Therefore, insufficient antibacterial effects can lead to bacterial proliferation and biofilm formation. Indeed, treating Enterococcus faecalis with subinhibitory antibiotic concentrations that inhibit cell wall synthesis increases cell lysis and extracellular DNA (eDNA) release, promoting biofilm formation [33]. Therefore, the increased biofilm formation in the T5 and T12 groups suggests insufficient antibacterial effects, prompting the bacteria to form biofilms as a survival strategy. These findings emphasize the need to analyze the combined effects of toothpaste ingredients at different concentrations on biofilm formation.

Figure 3.
Effects of toothpaste on biofilm formation of S. mutans. Biofilm formation of S. mutans in biofilm medium treated with (a) 0.5 mg/mL or (b) 0.75 mg/mL toothpaste was quantified at OD570. C: control without toothpaste treatment, NaF control: treated with 300 µg/mL NaF. The results are presented as the mean ± standard deviation (error bars) of three isolates, each assayed in triplicate. Statistical significance was determined using a paired sample t-test, with significance defined as p < 0.05 (*).
3.4. S. mutans Growth Curves as a Function of Toothpaste Treatment Concentration
To assess whether toothpaste inhibits bacterial growth or its components directly inhibit biofilm formation, the growth curves of S. mutans in BHI medium supplemented with toothpaste were evaluated. A tendency for reduced bacterial growth was observed at 0.5 mg/mL compared with the control group (Figure 4a). At 0.75 mg/mL, T1 and T3 completely inhibited S. mutans growth (Figure 4b; p < 0.05), consistent with their MIC values, demonstrating excellent antibacterial activity. Treatment with T7 or T9 increased the doubling time of S. mutans by approximately 2.8 and 1.5 times, respectively, compared to the control, reducing final cell counts. However, compared with the NaF control, T7 and T9 exhibited relatively low growth inhibition. Other toothpaste treatments had similar doubling times to the control but resulted in decreased final cell counts. At 1 mg/mL, all toothpastes, excluding T12, delayed or inhibited S. mutans growth (Figure 4c). Considering that the MBC of T12 exceeded 30 mg/mL, no significant growth inhibition was observed. T12—a natural toothpaste without sodium lauryl sulfate (SLS)—likely exhibited reduced antimicrobial activity due to the absence of SLS, which reduces the surface tension of plaque [34], and increases cell wall permeability, promoting the efflux of intracellular components and inducing cell lysis, thus inhibiting microbial growth [8,35,36].

Figure 4.
Growth curves of S. mutans in response to treatment with toothpastes at different concentrations. S. mutans was cultured in media treated with different concentrations of toothpaste for 24 h. Growth in media treated with (a) 0.5 mg/mL, (b) 0.75 mg/mL, and (c) 1 mg/mL toothpaste. NaF was used as a control at 300 µg/mL.
Based on growth curve and biofilm-forming assays, T1 and T3 effectively inhibited bacterial growth starting at 0.75 mg/mL, and T7 and T9 at 1 mg/mL. These toothpastes also inhibited biofilm formation at 0.5 mg/mL, suggesting a relationship between bacterial growth inhibition and biofilm reduction.
3.5. Altered Biofilm-Related Gene Expression of S. mutans Due to Toothpaste Application
The expression of key genes related to adhesion and biofilm (spaP, gtfB, gtfC, and gtfD) in S. mutans was analyzed via qRT-PCR following toothpaste treatment [15]. spaP encodes the P1 protein associated with S. mutans adhesion to tooth surfaces and initial biofilm formation [37]. Meanwhile, gtfB, gtfC, and gtfD encode glucosyltransferase enzymes essential for biofilm formation. gtfC synthesizes water-soluble glucan as a primer for the adhesive insoluble glucan produced by gtfB, while gtfD produces water-soluble glucans to support biofilm formation [38].
Statistically significant differences in gene expression following toothpaste treatment were evaluated based on the untreated control group, selecting genes with significant (≥2 fold) changes in expression for further analysis (Figure 5; p < 0.05). For the spaP gene, expression significantly decreased by 0.34 fold in T5 and 0.35 fold in T7, whereas expression increased by 2.47 fold under T9 treatment (Figure 5a; p < 0.05). gtfB expression decreased by 0.51 fold in T5 and increased by 1.62 fold in T9 (Figure 5b). gtfC expression significantly decreased by 0.32 fold in T2 and 0.16 fold in T5, and increased by 1.66 fold in the T9 group (Figure 5c; p < 0.05). For gtfD, expression decreased significantly by 0.19 fold in T5 and 0.40 fold in T7, whereas it increased significantly by 2.42 fold in T9 (Figure 5d; p < 0.05).

Figure 5.
Effects of toothpaste on biofilm-related gene expression in S. mutans. mRNA levels of (a) spaP, (b) gtfB, (c) gtfC, and (d) gtfD. Statistical significance was determined using Student’s t-test, with significance defined as *p* < 0.05 (*); genes with fold change ≥ 2 were considered significantly differentially expressed.
Differences between the gene expression results and biofilm formation experiments may be related to the bacterial response to high toothpaste concentrations, suggesting complex regulatory mechanisms are involved in bacterial growth and biofilm formation, considering the effects of toothpaste components. For example, T12, which induced high biofilm formation without growth inhibition at 1 mg/mL, did not induce significant changes in gene expression. Certain toothpaste components may activate alternative regulatory mechanisms influencing biofilm formation. Since this process in S. mutans involves multiple regulatory pathways and genes, others are likely also impacted by toothpaste exposure beyond those evaluated here [39,40,41]. The limited scope of gene expression profiling may have contributed to the lack of direct correlation between transcriptional changes and phenotypic biofilm formation. These findings highlight the need for broader molecular analyses to more fully capture the regulatory dynamics involved. Comprehensive transcriptomic approaches, such as RNA-seq, would provide a more holistic view of how toothpaste components influence gene expression and biofilm development at the systems level. The oral microbiome is highly diverse, and biofilm formation in the mouth is a multifactorial process driven by complex interspecies interactions. Therefore, simply suppressing S. mutans alone cannot provide a complete oral hygiene solution. The absence of this ecological context represents a limitation of our study. Furthermore, the use of BHI broth, a nutrient-rich laboratory medium, does not fully recapitulate the dynamic physicochemical and biological factors of the oral cavity. Thus, results obtained under in vitro conditions should be interpreted with caution, and further validation under more physiologically relevant models is warranted. Future research should broaden the gene panel to include virulence and stress response pathways and incorporate other clinically relevant oral microorganisms to elucidate the full spectrum of mechanisms by which toothpaste modulates biofilm formation.
4. Conclusions
This study aimed to evaluate the antibacterial and antibiofilm effects of various commercially available toothpastes and to explore their influence on the expression of biofilm-related genes in S. mutans. The results indicated that T1 and T3 toothpastes exhibited excellent antibacterial effects and biofilm inhibition on S. mutans, providing insights into how the components of each toothpaste influence biofilm formation. In particular, T1 toothpaste demonstrated antibacterial effects even at a certain fluoride concentration, whereas T3 toothpaste confirmed that hydrogen peroxide plays a key role in inhibiting biofilm formation.
Specific ingredients in functional toothpaste also regulate the expression of genes associated with biofilm formation. However, certain gene expression results did not align with the biofilm formation outcomes, suggesting that toothpaste ingredients may influence other regulatory mechanisms or genes involved in biofilm formation. For example, T5 showed relatively little change in the expression of key biofilm-associated genes, yet it exhibited substantial biofilm formation. This highlights the need to consider the inhibitory effects on gene expression and the impact on bacterial growth and biofilm formation when developing functional toothpastes. As the direct effect of antimicrobial agents on bacterial growth may influence biofilm formation, these properties should be considered in toothpaste formulations to optimize ingredient combinations.
Future research should aim to elucidate the antibacterial mechanisms of individual toothpaste ingredients and develop new ingredients that are more effective in inhibiting biofilm formation. While this study focused on S. mutans as a well-established cariogenic model, sustaining oral health will ultimately require approaches that consider the broader, multispecies oral microbiome rather than the suppression of a single species. This perspective can guide the development of more effective functional toothpastes to enhance oral health.
Author Contributions
Conceptualization, J.N.K.; methodology, Y.J.L. and J.N.K.; software, Y.J.L.; validation, Y.J.L. and J.N.K.; formal analysis, Y.J.L. and J.N.K.; investigation, Y.J.L. and J.N.K.; resources, J.N.K.; data curation, Y.J.L. and J.N.K.; writing—original draft preparation, Y.J.L. and J.N.K.; writing—review and editing, J.N.K.; visualization, Y.J.L. and J.N.K.; supervision, J.N.K.; funding acquisition, J.N.K. All authors have read and agreed to the published version of the manuscript.
Funding
This work was supported by a 2-year Research Grant of Pusan National University.
Institutional Review Board Statement
Not applicable.
Informed Consent Statement
Not applicable.
Data Availability Statement
The data supporting the findings of this study are available from the corresponding author upon reasonable request.
Conflicts of Interest
The authors declare no conflicts of interest.
References
- Loveren, C.V. Toothpastes; Monographs in Oral Science; Karger: Basel, Switzerland, 2013; pp. 9–19. [Google Scholar]
- Fischman, S.L. The history of oral hygiene products: How far have we come in 6000 years? Periodontology 2000 1997, 15, 7–14. [Google Scholar] [CrossRef]
- Unterbrink, P.; Schulze Zur Wiesche, E.; Meyer, F.; Fandrich, P.; Amaechi, B.T.; Enax, J. Prevention of Dental Caries: A Review on the Improvements of Toothpaste Formulations from 1900 to 2023. Dent. J. 2024, 12, 64. [Google Scholar] [CrossRef] [PubMed]
- Barbosa, L.M.M.; de Souza Carneiro, T.; Favoreto, M.W.; Borges, C.P.F.; Reis, A.; Meireles, S.S.; Loguercio, A.D. Whitening toothpastes with hydrogen peroxide concentrations vs. at-home bleaching. Clin. Oral Investig. 2024, 28, 436. [Google Scholar] [CrossRef]
- Tomas, D.B.M.; Pecci-Lloret, M.P.; Guerrero-Girones, J. Effectiveness and abrasiveness of activated charcoal as a whitening agent: A systematic review of in vitro studies. Ann. Anat. 2023, 245, 151998. [Google Scholar] [CrossRef]
- Petrovic, B.; Kojic, S.; Milic, L.; Luzio, A.; Peric, T.; Markovic, E.; Stojanovic, G.M. Toothpaste ingestion-evaluating the problem and ensuring safety: Systematic review and meta-analysis. Front. Public Health 2023, 11, 1279915. [Google Scholar] [CrossRef]
- Jardim, J.J.; Alves, L.S.; Maltz, M. The history and global market of oral home-care products. Braz. Oral Res. 2009, 23 (Suppl. S1), 17–22. [Google Scholar] [CrossRef] [PubMed][Green Version]
- Sabri, H.; Derakhshan Barjoei, M.M.; Azarm, A.; Sadighnia, N.; Shakiba, R.; Aghebati, G.; Hadilou, N.; Kheiri, P.; Ghanbari, F.; Deravi, N.; et al. The Yin and Yang of Sodium Lauryl Sulfate Use for Oral and Periodontal Health: A Literature Review. J. Dent. 2023, 24, 262–276. Available online: https://dentjods.sums.ac.ir/article_48882.html (accessed on 15 May 2025).
- Liao, Y.; Brandt, B.W.; Li, J.; Crielaard, W.; Van Loveren, C.; Deng, D.M. Fluoride resistance in Streptococcus mutans: A mini review. J. Oral Microbiol. 2017, 9, 1344509. [Google Scholar] [CrossRef]
- Jones, S.; Burt, B.A.; Petersen, P.E.; Lennon, M.A. The effective use of fluorides in public health. Bull. World Health Organ. 2005, 83, 670–676. [Google Scholar]
- Daruich, P.M.; Brizuela, M. Remineralization of Initial Carious Lesions. In StatPearls; StatPearls Publishing: Treasure Island, FL, USA, 2025. [Google Scholar]
- Ucuncu, M.K.; Guven, K.; Yazicioglu, O. Investigation of the constituents of commercially available toothpastes. Int. J. Dent. Hyg. 2024, 22, 913–932. [Google Scholar] [CrossRef]
- Scharnow, A.M.; Solinski, A.E.; Wuest, W.M. Targeting S. mutans biofilms: A perspective on preventing dental caries. MedChemComm 2019, 10, 1057–1067. [Google Scholar] [CrossRef]
- Manzer, H.S.; Nobbs, A.H.; Doran, K.S. The Multifaceted Nature of Streptococcal Antigen I/II Proteins in Colonization and Disease Pathogenesis. Front. Microbiol. 2020, 11, 602305. [Google Scholar] [CrossRef]
- Bowen, W.H.; Koo, H. Biology of Streptococcus mutans-derived glucosyltransferases: Role in extracellular matrix formation of cariogenic biofilms. Caries Res. 2011, 45, 69–86. [Google Scholar] [CrossRef]
- Marquis, R.E. Antimicrobial actions of fluoride for oral bacteria. Can. J. Microbiol. 1995, 41, 955–964. [Google Scholar] [CrossRef] [PubMed]
- Belli, W.A.; Buckley, D.H.; Marquis, R.E. Weak acid effects and fluoride inhibition of glycolysis by Streptococcus mutans GS-5. Can. J. Microbiol. 1995, 41, 785–791. [Google Scholar] [CrossRef] [PubMed]
- Li, C.; Qi, C.; Yang, S.; Li, Z.; Ren, B.; Li, J.; Zhou, X.; Cai, H.; Xu, X.; Peng, X. F0F1-ATPase Contributes to the Fluoride Tolerance and Cariogenicity of Streptococcus mutans. Front. Microbiol. 2021, 12, 777504. [Google Scholar] [CrossRef]
- Lee, Y.C.; Cho, S.G.; Kim, S.W.; Kim, J.N. Anticariogenic Potential of Korean Native Plant Extracts against Streptococcus mutans. Planta Medica 2019, 85, 1242–1252. [Google Scholar] [CrossRef]
- Pulfer, A.M.; Attin, T.; Wegehaupt, F.J. Salivary Flow Rate During Toothbrushing. Oral Health Prev. Dent. 2022, 20, 465–474. [Google Scholar] [CrossRef] [PubMed]
- Ahn, S.J.; Lemos, J.A.; Burne, R.A. Role of HtrA in growth and competence of Streptococcus mutans UA159. J. Bacteriol. 2005, 187, 3028–3038. [Google Scholar] [CrossRef]
- Kim, J.N.; Stanhope, M.J.; Burne, R.A. Core-gene-encoded peptide regulating virulence-associated traits in Streptococcus mutans. J. Bacteriol. 2013, 195, 2912–2920. [Google Scholar] [CrossRef]
- Loo, C.Y.; Corliss, D.A.; Ganeshkumar, N. Streptococcus gordonii biofilm formation: Identification of genes that code for biofilm phenotypes. J. Bacteriol. 2000, 182, 1374–1382. [Google Scholar] [CrossRef]
- Piszko, P.J.; Piszko, A.; Kiryk, S.; Kiryk, J.; Kensy, J.; Michalak, M.; Matys, J.; Dobrzynski, M. Fluoride Release from Two Commercially Available Dental Fluoride Gels-In Vitro Study. Gels 2025, 11, 135. [Google Scholar] [CrossRef]
- Silhacek, K.J.; Taake, K.R. Sodium bicarbonate and hydrogen peroxide: The effect on the growth of Streptococcus mutans. J. Dent. Hyg. 2005, 79, 7. [Google Scholar]
- Cheng, X.; Xu, X.; Zhou, X.; Ning, J. Oxidative stress response: A critical factor affecting the ecological competitiveness of Streptococcus mutans. J. Oral Microbiol. 2024, 16, 2292539. [Google Scholar] [CrossRef]
- Biria, M.; Rezvani, Y.; Roodgarian, R.; Rabbani, A.; Iranparvar, P. Antibacterial effect of an herbal toothpaste containing Bamboo salt: A randomized double-blinded controlled clinical trial. BMC Oral Health 2022, 22, 193. [Google Scholar] [CrossRef]
- Kumar, P.S.; Vidhya, S.; Sekar, M. Depth of Penetration and Antimicrobial Activity of 5% and 10% Bamboo Salt, 2% Chlorhexidine Gel and Calcium Hydroxide Against Enterococcus faecalis—An In Vitro Study. Eur. Endod. J. 2021, 6, 205–210. [Google Scholar] [CrossRef]
- Randall, J.P.; Seow, W.K.; Walsh, L.J. Antibacterial activity of fluoride compounds and herbal toothpastes on Streptococcus mutans: An in vitro study. Aust. Dent. J. 2015, 60, 368–374. [Google Scholar] [CrossRef] [PubMed]
- Klaophimai, A.; Tosrisawatkasem, O.; Horsophonphong, S. Antibacterial effects of children’s and adults’ toothpastes containing different amounts of fluoride: An in vitro study. J. Dent. Res. Dent. Clin. Dent. Prospect. 2024, 18, 23–28. [Google Scholar] [CrossRef]
- Han, Y. Effects of brief sodium fluoride treatments on the growth of early and mature cariogenic biofilms. Sci. Rep. 2021, 11, 18290. [Google Scholar] [CrossRef] [PubMed]
- Raval, Y.S.; Flurin, L.; Mohamed, A.; Greenwood-Quaintance, K.E.; Beyenal, H.; Patel, R. Antibacterial Activity of Hydrogen Peroxide and Hypochlorous Acid, Including That Generated by Electrochemical Scaffolds. Antimicrob. Agents Chemother. 2021, 65, e01966-20. [Google Scholar] [CrossRef] [PubMed]
- Yu, W.; Hallinen, K.M.; Wood, K.B. Interplay between Antibiotic Efficacy and Drug-Induced Lysis Underlies Enhanced Biofilm Formation at Subinhibitory Drug Concentrations. Antimicrob. Agents Chemother. 2018, 62, e01603-17. [Google Scholar] [CrossRef]
- Petersen, F.C.; Assev, S.; Scheie, A.A. Combined effects of NaF and SLS on acid- and polysaccharide-formation of biofilm and planktonic cells. Arch. Oral Biol. 2006, 51, 665–671. [Google Scholar] [CrossRef]
- Shi, Q.; Sun, L.; Gao, J.; Li, F.; Chen, D.; Shi, T.; Tan, Y.; Chang, H.; Liu, X.; Kang, J.; et al. Effects of sodium lauryl sulfate and postbiotic toothpaste on oral microecology. J. Oral Microbiol. 2024, 16, 2372224. [Google Scholar] [CrossRef] [PubMed]
- Aydin, N.; Suloglu, A.K.; Idil, N.; Ozturk, S.; Karaoglanoglu, S. Examination of cytotoxic and antimicrobial effect of whitening toothpastes: An in vitro study. Acta Odontol. Scand. 2024, 83, 327–333. [Google Scholar] [CrossRef]
- Brady, L.J.; Maddocks, S.E.; Larson, M.R.; Forsgren, N.; Persson, K.; Deivanayagam, C.C.; Jenkinson, H.F. The changing faces of Streptococcus antigen I/II polypeptide family adhesins. Mol. Microbiol. 2010, 77, 276–286. [Google Scholar] [CrossRef] [PubMed]
- Koo, H.; Falsetta, M.L.; Klein, M.I. The exopolysaccharide matrix: A virulence determinant of cariogenic biofilm. J. Dent. Res. 2013, 92, 1065–1073. [Google Scholar] [CrossRef]
- Zheng, T.; Jing, M.; Gong, T.; Yan, J.; Wang, X.; Xu, M.; Zhou, X.; Zeng, J.; Li, Y. Regulatory mechanisms of exopolysaccharide synthesis and biofilm formation in Streptococcus mutans. J. Oral Microbiol. 2023, 15, 2225257. [Google Scholar] [CrossRef]
- Lemos, J.A.; Burne, R.A. A model of efficiency: Stress tolerance by Streptococcus mutans. Microbiology 2008, 154 Pt 11, 3247–3255. [Google Scholar] [CrossRef]
- Senadheera, D.; Cvitkovitch, D.G. Quorum sensing and biofilm formation by Streptococcus mutans. Adv. Exp. Med. Biol. 2008, 631, 178–188. [Google Scholar] [CrossRef] [PubMed]
Disclaimer/Publisher’s Note: The statements, opinions and data contained in all publications are solely those of the individual author(s) and contributor(s) and not of MDPI and/or the editor(s). MDPI and/or the editor(s) disclaim responsibility for any injury to people or property resulting from any ideas, methods, instructions or products referred to in the content. |
© 2025 by the authors. Licensee MDPI, Basel, Switzerland. This article is an open access article distributed under the terms and conditions of the Creative Commons Attribution (CC BY) license (https://creativecommons.org/licenses/by/4.0/).